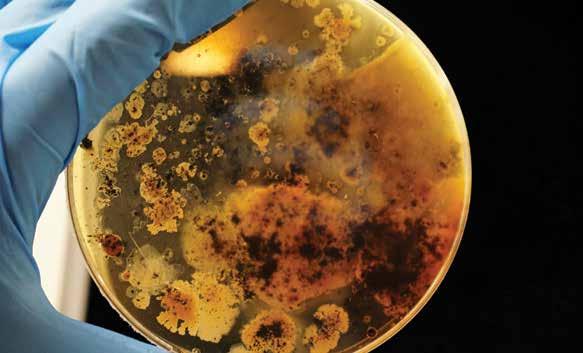

Traditionally, lubricants have been treated as consumables which can easily be discarded and replaced at specified intervals. However, with the changes in the economy, the fluctuating prices of natural resources and the impact of processing these products on the environment, these should no longer be treated as consumables. Viewing lubes as assets is the first step in extending the life of the lubricant as well as the equipment. Engineers can set you up with the right high-performance lubricant for the application and show you how to keep it clean and dry with reliability products and services.

While reducing energy or fuel consumption is an important aspect of any lubrication sustainability policy, so too is reducing the amount of oil or grease that is used. Using less oil or grease means less oil production, fewer carbon emissions, and less waste that requires disposal.
Many organizations are moving their asset-management policies toward the ISO 55000 standard, with sustainability as a firm pillar of the standard. This provides a prescriptive series of recommendations for precision lubrication and lubrication sustainability.
One of the fundamental tenets of ISO 55000 and ICML 55 is the definition of an

asset beyond a machine to anything that has tangible value to the organization. By that definition, a lubricant should be considered an asset since the effectiveness of the lubricant can have a profound impact on equipment life and energy usage. Gone are the days when oil was considered to be a consumable, purchased at the lowest price and changed out on a whim. The health, well-being, and cleanliness of the lubricant should be nurtured to extract maximum value from this important asset.
Most OEMs specify an oil-change interval for new equipment. For the large part, these recommendations are very conservative, with good reason. No OEM is going to recommend a two-year (or longer) oil drain if there is even a remote chance that, in doing so, the equipment may fail, resulting in a warranty claim. The old (incorrect) adage that “new oil is cheap insurance” is still held near and dear by many OEMs.
OEM oil-change intervals can often be safely extended by as much as two to five times, provided a quality lubricant is used, and the health of the lubricant is monitored. To ensure that oil or grease is fit for continued use the fluid analysis should be used. Critical tests, such as acid and base number, oil oxidation and oxidation potential as well as, additive health, can all be measured and should be
used to change behaviors from time-based to on-condition oil changes.
Online oil-quality sensors can also be effective in helping to time oil changes based on fluid health. Unlike the algorithms used by many automotive manufacturers to signal the time for an oil change, these are actual sensors that use changes in fluid conductivity or permittivity to detect changes in base oil and/or additive chemistry. By monitoring oil health in real-time using a sensor, the data can also be correlated with the operational aspect of the component in question.
We thank the readers for their feedback and suggestions on articles and case studies that they want us to cover in the magazine. We look forward to the continued patronage of the advertisers and the subscribers.
Warm regards,
Udey DhirChanging to a more reliable lubricant supply may be your best bet.”

In the past couple of years, Noria has received a slew of requests for help from large users needing backup lubricants for critical applications.
Disruptions in lubricant supply have been the main impetus for these inquiries. As we talked to many industry contacts, we discovered that the problem is widespread. A shortage of additive stock appears to be the

main culprit, but in other cases, base oil supply-chain issues were responsible.
Some users have been attempting to deploy stopgap solutions to reduce oil consumption. This includes extending oil drains and doing top-ups as opposed to oil changes. Of course, one way to get oil to last longer is by reducing additive and base oil distress using the clean/dry/cool strategy.
In other cases, supplemental additives can be reconstituted into the aging lubricant — something like a booster shot. However, that assumes those additives can be made available.
It may also be wise to keep larger reserves on hand by doing away with just-in-time inventory management until reliable supplies return. Note that the prolonged storage of lubricants may present
acute problems as well. Do your homework on storage stability issues from past articles found at machinerylubrication.com.
However, these strategies may be nothing more than a temporary fix to chronic future problems. Changing to a more reliable lubricant supply may be your best bet. At a minimum, you need to be “at the ready” with a backup lubricant that is immediately deployable in your plant equipment when the need arises. Don’t wait until you’re down to your last drop; think through the worst-case scenarios and the contingency
plans or remedies that you have at your disposal.

If a lubricant change is possible (or, for whatever reason, unavoidable), it is best to get a firm grasp on the potential risks. Your ace in the hole may not be all that it seems. Verification is absolutely necessary. Fortunately, the industry has considerable experience and understands the risks associated with a sudden changeover to a
Publisher Udey Dhir udeydhir@tribologysolutions.com
Creative Director Sumita Maniktala smassociates@gmail.com
Advertisement Sales (US/Canada) Brett O'Kelley - bokelley@noria.com
Advertisement Sales (India/all other countries)
Kaustav Das kaustuvdas@machinerylubricationindia.com
CORRESPONDENCE
You may address articles, case studies, special requests and other correspondence to our
Operation office :
Editor 213, Ashiana Centre, Adityapur, Jamshedpur-831013, India
email : editor@machinerylubricationindia.com
Tel: +91-657-2383238
Tel:(USA): +1-918-960-9738
Marketing Office
Rider House, 136, Sector 44, Gurgaon-122003, Haryana National Capital Region, India
Machinery Lubrication India Volume 63 - Issue 2, March-April 2023 is published bi-monthly by VAS Tribology Solutions Pvt. Ltd. Operation Office:213, Ashiana Centre, Adityapur, Jamshedpur-831013, India.
SUBSCRIBER SERVICES: The publisher reserves the right to accept or reject any subscription. Send subscription orders, change of address and all related correspondence to: VAS Tribology Solutions Pvt. Ltd. Operation Office:213, Ashiana Centre, Adityapur, Jamshedpur-831013, India.
Copyright © 2013 VAS Tribology Solutions Pvt. Ltd., Machinery Lubrication India and associated logos are trademark of VAS Tribology Solutions Pvt. Ltd. All rights reserved. Reproduction in whole or in any part in any form or medium without express written permission of VAS Tribology Solutions Pvt. Ltd. is prohibited. VAS Tribology Solutions Pvt. Ltd. reserves the right with respect to submission, to revise, republish and unauthorize its readers to use the tips and articles submitted for personal and commercial use. The opinions of those interviewed and those who write articles for this magazine are not necessarily shared or endorsed by VAS Tribology Solutions Pvt. Ltd.
CONTENT NOTICE: The recommendation and information provided in Machinery Lubrication India and its related properties do not purport to address all of the safety concern that may exist. It is the responsibility of the users to follow appropriate safety and health practices. Further, Machinery Lubrication India does not make any representations of warranties, express or implied, regarding the accuracy, completeness or suitability, of the information or recommendations provided herewith. Machinery Lubrication India shall not be liable for any injuries, loss of profits, business, goodwill, data, interruption of business, nor for incidental or consequential merchantability or fitness of purpose, or damages related to the use of information or recommendations provided.
backup lubricant. These include:
• The backup lubricant was incompatible with the previous lubricant, and some mixing was unavoidable (or not properly avoided). The incompatibility resulted in lubricant performance defects and associated reliability consequences.
• The backup lubricant was incompatible with internal sediment, sludge and/or varnish.
• The backup lubricant was incompatible with internal machine surfaces (paint, surface treatments, filters, elastomers, caulking, adhesives, etc.). Some aggressive lubricant additives can leach sensitive metals (tin or copper, for instance).
• The backup lubricant was incompatible with operating conditions and exposures (temperature extremes, contaminants, gases, process chemicals, washdown sprays, coolants, etc.).
• The backup lubricant had performance weaknesses or drawbacks that the previous lubricant did not. While some characteristics of the new lubricant may be superior to the previous lubricant, many others could exhibit
Loss of oil clotting/ packing
Old machines; switching from mineral oil to formulations with esters, detergents, dispersants and other polar additives
Oil leakage (both internal and external) and potential starvation
Perform a chemical flush and repair leakage before the machine is returned to service
Impaired seal performance (e.g., dimension change, structural change, deterioration, compression set issues, etc.)
Old machines; switching to a synthetic lubricant that has a sharply different aniline point than the previous lubricant
Oil leakage (both internal and external) and potential starvation
Run tests for compatibility to elastomer types used in the machine; repair/ replace old and worn seals
Sludge mobility (sludge and deposits become mobilized by change in lubricant chemistry)
Old machines; switching from mineral oil to formulations with esters, detergents, dispersants and other polar additives
Clogged oil flow through glands and orifices resulting in starvation and accelerated wear
High-velocity flush, chemical flush and other flushing methods needed to purge system of sludge and deposits before new lubricant is introduced
Impaired lubricant performance due to clashing additives and base oils
Incompatible lubricant mixtures such as acid/ base reactions
Possible reliability issues from:

• Production of sludge and other insolubles
• Loss of interfacial tension leading to chronic aeration problems, foam and/ or oil-water emulsions
• Impaired oxidation stability
• Corrosion
• Impaired film strengh
Complete drain and flush of all remnants of the previous lubricant
substandard performance.
The highest risks coming from backup lubricant changeovers are associated with:
• Old equipment (long service with the previous lubricant)
• Unknown additive chemistry and limited compatibility testing performed
• High machine duty and criticality
• Complex lubricant formulations
There are numerous industry standards that provide guidance on compatibility testing (ASTM, FTC, etc.). The typical protocol for oil (e.g., ASTM D7155) involves preparing binary mixtures of the lubricants with questionable compatibility. Mixtures such as 50:50, 95:5 and 5:95 are often used, but this can be modified to better match the target application.
According to ASTM D7155, the mixtures must go through a short bedding-in time at an elevated temperature. This allows the base oil and additives to chemically and physically interact, after which the mixtures are ready to be inspected and tested further. If floc, sediment, clouding or discoloration develops from the mixtures, the lubricants are confirmed to be incompatible (tier-one test) without further analysis. If this doesn’t occur, a sequence of additional testing tiers will be required. The exact tests and passing conditions associated with these supplemental tiers must be thought through carefully (lubricant, application and exposure dependent).
Machine criticality plays a vital role in this decision, along with other factors. A lubricant specification can be used as the baseline for the supplemental tests, or the performance listed on the new lubricant from its product data sheet can be used. However, a well-constructed specification is necessary for critical applications. Example performance tests can include filterability,
air-handling ability, water-handling ability, film strength, oxidation stability, corrosion suppression, etc.
The selection of tests for the supplemental tiers is largely driven by service life needs (of the oil) and the critical performance needs in the target machine application. Again, standardized test methods can be employed, especially relating to elastomers and surface treatments. The risks relating to chemical exposures might include certain gases (refrigerants, ammonia, hydrogen sulfide, etc.), fuel, coolants, process chemicals, etc. Custom or modified standardized testing may also need to be performed to assess their compatibility.
For obvious reasons, a changeover is strongly discouraged if incompatibility is found (or there is uncertainty) between the new backup lubricant and the machine (seals, for instance) or the operating environment (e.g., process gases) (see Figure 1). If a changeover is still unavoidable, seek other lubricant options to mitigate the risks and consequences. Do not underestimate the importance of this.
Should incompatibility only be found between the lubricant mixtures (not the machine or operating exposures), a changeover can usually be successfully performed. However, this requires special precautions, such as the complete removal of the previous lubricant and the decontamination of sediment, sludge and varnish.
The greater the danger, the more rigorous the drain and flushing procedure should be. We can relate this to the definition of risk, which is the probability of a compatibility problem multiplied by the consequences of incompatibility. High lubricant incompatibility (determined from testing) relates to the probability of a problem occurring, and high machine criticality
defines the consequences of failure (lubricant and/or machine). Criticality includes such things as the cost of repair, lost production, the cost of flushing and safety risks.
Where the danger is the highest, drain the system completely of all remnants of the previous fluid. Look for trapped cavities of fluid in heaters, coolers, off-line loops, hoses, filters, low-point traps, line extensions, etc. Even after the drain is complete, oil will still occlude to the internal machine surfaces. These wet surfaces, along with the presence of sludge and surface deposits (including varnish), are high risk.
Follow the drain with a displacement or chase fluid to carry away the remaining previous oil. The displacement fluid is sacrificial and, as such, needs to be completely compatible with the final fluid charge and relatively inexpensive. A low-viscosity base oil is sometimes used, or perhaps even a transformer oil. Heating the displacement fluid and passing it through all internal fluid zones at high velocity (high Reynolds Number) gives the best results. Many independent companies offer flushing services that are worth considering.
If machine surfaces fail to clean completely, a chemical flush may be required. This can be added to the displacement fluid at a concentration of 5%-10%. One common product sold by DuBois Chemicals is Step-One cleaner (also branded and available from other lubricant suppliers). It is not a solvent but a calcium-sulfonate detergent product blended in a mineral base oil that has been found to be very effective. One drawback is that this cleaner must be completely removed from the system before the final lubricant is introduced. This is typically done with yet another displacement fluid.
After the flush has been completed and the final oil charge added, combat the law of unintended consequences by using a post-changeover monitoring strategy. Accelerate oil analysis and other machine inspections (foam, cloudy sight glasses, high temperature, discoloration, noisy operation, etc.) — test for foaming tendency and demulsibility characteristics.

Also, don’t forget to change lubrication procedures to include the new lubricant for top-ups and oil changes. Be sure to re-label the machine with the correct new lubricant as well. ML
Jim Fitch has a wealth of “in the trenches” experience in lubrication, oil analysis, tribology and machinery failure investigations. Over the past two decades,
he has presented hundreds of courses on these subjects. Jim has also published more than 200 technical articles, papers and publications. He serves as a U.S. delegate to the ISO tribology and oil analysis working group. Since 2002, he has been the director and a board member of the International Council for Machinery Lubrication. He is the CEO and a co-founder of Noria Corporation. Contact Jim at jfitch@noria. com.
 By Noria Media
By Noria Media
While sending oil or fluid samples off to the lab is a great way to verify the cleanliness of your fluids and the health of your equipment, the process takes time. Online particle counting is faster, but you may have to trade a certain amount of accuracy for that speed. Cost also will play a role in making the best decision for your needs and application.
(RCC), it’s a combination of technological tools and human inspection that delivers the best results for his clients, and he’s come a long way from the early days in the industry.
“My first particle counter 20 years ago was worth more than my car,” Wayne said, laughing.
Contamination ControlBut for Wayne Hubball, Technical Director at Reynolds
We spoke with Hubball about a system that has brought powerful insights and a high level of cleanliness to mining operations,
“MY FIRST PARTICLE COUNTER 20 YEARS AGO WAS WORTH MORE THAN MY CAR”
fuel providers, and even Formula One™ racing teams. We also covered the role that traditional oil or fluid sampling plays in the process and how RCC developed a mobile flushing package that brings it all together.
While Reynolds Contamination Control offers flushing and fluid monitoring for a range of fuel and fluid systems, it was their experience developing tailor-made sensor and flushing systems for specialized
applications that caught the eye of their most speed-obsessed customers.
One of the core elements of their solution is called The Link, a real-time fluid condition monitoring system that allows users to have an instant, quite holistic picture of their assets, including fuels, coolants, oils or other fluids they depend on.
Because the system is mobile, batterypowered, and can handle a range of different fluids and applications, it was the perfect
fit for a type of customer that demands performance, reliability and cleanliness at the highest levels — Formula One racing teams.
If you’re familiar with Formula One, you probably already know that the profitability of a racing team and the reliability of their race cars go hand in hand. Each “Constructor” (the teams who design,

build and race two new cars each year) has a budget cap of $140 million to create their cars. Estimates for the total revenue generated by the sport for 2021 are around $2.14 billion.
Much like equipment downtime in a plant or mine site, if a Formula One car is not performing properly, the team stands to lose a huge amount of money in a very small amount of time — the difference between finishing 1st versus finishing 2nd in a Grand Prix might be a tenth of a second that costs the team $10 million or more in lost earnings, depending on overall standings. Every aspect of the car must be at peak performance on race day — but even the fastest car in the world will not win championships if it is not highly reliable. But how do fluid monitoring and flushing
fit into that picture?
Formula One cars don’t just have an internal combustion engine; they have what is known as a Power Unit or PU. The PU brings together both internal combustion power and electrical power to give cars the ability to “harvest” energy and store it in the Energy Storage System (ESS) strategically during one lap to then release it in another, giving the car an electrical speed boost on command.
This system uses a lithium-ion battery that must perform under extreme conditions — not just at high speeds but in drastically different environments around the world. One week a Grand Prix might be cool and rainy in Canada, with another race in the desert environment of Saudi Arabia two weeks later.
In both environments, the battery has to be kept at the optimal temperature through cycles of charging and discharging during a race. But one racing team was struggling with a chronic fluid contamination problem, and they were spending over two hours flushing and filtering the system only to fail to achieve the Recommended Cleanliness Level (RCL) time and again, so they called Wayne.



If you’re a regular reader of Machinery Lubrication, you can probably spot that Reynolds Contamination Control takes their company name from a hero of hydrodynamics, Osborne Reynolds.


Born in Belfast, Ireland, Osborne Reynolds (August 23, 1842 - February 21, 1912) was a British fluid dynamics engineer who studied conditions in which the flow of fluid in pipes transitioned from laminar to turbulent. The result of Reynolds' studies was a dimensionless number (Reynolds Number) representing the ratio of inertial forces to viscous forces. Flow typically changes from laminar to turbulent between Reynolds numbers 2,000 and 4,000. Turbulent flow, with a high Reynolds number, sharply improves the effectiveness of flushing tasks.

“ONE RACING TEAM WAS STRUGGLING WITH A CHRONIC FLUID CONTAMINATION PROBLEM”

RCC’s v fit the bill perfectly, and this particular rig was outfitted with 23 different sensors, monitoring temperature, fluid level, flow, filter differential, pressure, particle counts, relative humidity and water content. Its ability to both monitor and clean the temperature control fluid (sometimes a water/glycol mixture, but in this case a fully synthetic PAO) while outputting detailed data to a cloud dashboard was just what the team needed. They also needed help selecting the right Beta-rated filters to properly remove the fluid-borne contaminants to cut down on flushing time between races.
During flushing, RCC made sure that the flow rate gave a Reynolds number greater than 4100 to achieve turbulent flow without causing a pressure increase above 1 bar. Temperature was also a concern, needing to maintain under 48 C. The recommended cleanliness level target was SAE AS 4059 REV F cpc 6. The cpc in this code stands for Cumulative Particle Count.
During the filterability trial, RCC installed two offline filter housings fitted with 3-micron media on the flush line and return line combined with a breather on the reservoir. When the first sample was taken from the battery pre-filter’s return line, a cleanliness level of SAE AS4059F cpc 11 was found.
After flushing, onboard particle counters read a final cleanliness level of SAE AS4059F cpc 2, and this result was achieved in a flushing cycle averaging 24 minutes rather than 2 hours. In an environment where time is critical, both on and off the race track, these results were just what the team needed.
But, as mentioned above, it is always a good idea to verify onsite oil or fluid analysis results through sampling and lab testing. Fortunately, Wayne had that covered as well with the help of a Luneta Condition

Monitoring Pod (CMP) installed on the flushing rig’s reservoir.
Making it fast and simple to inspect fluid visually and take reliably clean samples day in and day out helps encourage good practices, allowing users to verify onsite analysis and catch obvious problems visually before they lead to failure. Hubball says it fits right in with his vision for RCC’s systems.
“It just makes life so much easier,” Hubball said, “What’s in the reservoir? What’s going on visually? Bringing in the Condition Monitoring Pod was really about the easeof-use for us and how we integrate it into the day-to-day process of taking verification samples. We wanted to provide clients a full package solution, and the Luneta CMP helps us do that.”
Anyone who is responsible for the reliability or maintenance of a critical machine (even one that does not travel at triple-digit speeds around hairpin turns) can glean a useful lesson from the world of Formula One: Even when speed is an absolute priority, and you have all the cutting-edge condition monitoring technology you could need, simple visual inspections and laboratory results still play a vital role in any serious reliability or maintenance effort. ML
Using a sight glass like the Luneta CMP gives operators and technicians a visible inspection window into the condition of lubricants and machines. Users can quickly inspect oil level, color and clarity, oil aeration and foaming corrosion, varnish, wear debris and other key inspections. Adding a sight glass to your equipment can provide valuable insights without adding significant costs, improving your chances of identifying root causes and symptoms of failure before they lead to unplanned downtime.
More
Factor:
S4M — Consolidation and Optimization
Level:
Platform(M)
Stage:

Lubricant Selection
About:
Paul Farless | Noria Corporation
Condition Monitoring, Lubricant Analysis & Troubleshooting LUBRICANT SELECTION

Lubricant Consolidation and Optimization: Which Lubes Stay and Which Lubes Go?
Learn More: noria.com/ascend/
Generally, in any given lube room we will see some of the current lubricants and a dozen or so other lubricants shoved in the back corner that haven’t been seen or heard from in years. Yet those old lubricants are still part of the lube list we receive before data collection for our LPD2 service. This can be confusing for a new technician, and we’re there to help resolve that confusion. Before we do that, there are a few steps we must first take in order to figure out which lubri-
Survey every lubricated machine and component in the entire facility and identify the lubricants that are in use. We also collect pertinent data from each machine; for electric motors, we may collect HP, speed, frame size and other operational and environmental data. This can be very difficult in some plants, depending on their age and if they have attempted lubricant consolidation or other lube program developments in the past.
Next, collect the name, make and type of every lubricant in the lube room, as well as lubricants found randomly throughout the plant. This list can then be combined with the list of lubricants created in STEP 1 to form a complete list of lubricants in the facility. Once we have figured out all of the current lubricants in each machine and component, we will have collected the necessary data for making our own recommendations of what lubricants should be utilized in each machine.
Next, we take all of that data back to our home base and study each machine and component to outfit it with hardware, recommended lubricant, sampling, inspections, etc.
We then consider all of the collected information and come to a recommendation for all of the greased components and all of the oiled components.
Once the recommendations are formulated, they are sent to the facility for approval by the stakeholders involved. Explanations are provided, and a review is done for this approval process. Once the lubricants are approved, we are also left with a list of lubricants that are no longer utilized but still remain in the plant.

cants stay and which lubricants go.
We advise the company to properly dispose of all the lubricants that are not in use. This has two benefits: it opens up space in the lube room for current and recommended lubricants and ensures that the incorrect lubricants randomly found throughout the plant are not accidentally used.
We align our recommended lubricants with the current lubricants in use and all of the lubricants on site. We recommend lubricants based on a codified approach called a Lubricant Identification System (LIS) Code. This allows us to recommend viscosity, additive package, base oil type and application without being brand-specific — Noria is a vendor-neutral company.
For this step, we must take into account the compatibility of the current lubricant and the recommended lubricant. For example, you don’t want to purge a bearing with an aluminum complex thickened grease if there is a calcium thickener in the current grease.
Now that we have eliminated the unused and outdated lubricants on-site, it is time to optimize the lubricants that are on-site. We often tell the end-users that “consolidation” isn’t necessarily the right word to use. Instead, “optimization” is much more accurate. This means that not only do you “sometimes” have fewer lubricants on-site, but you now have the correct lubricants on-site. I put “sometimes” in quotations because sometimes the lubricant consolidation process will end with the same number of lubricants or near the same amount as before. Some may have been removed, and some might have been added, but the result is an optimized selection of lubricants, ensuring the right lubricant is selected for each machine.
We optimize a lube list by assigning specific greases and oils based on the machine data and operational and environmental parameters. This could mean that now the facility only utilizes four greases instead of eight greases; one for high-speed, one for low-speed, one for couplings and one for electric motors, for example. However, that is not always the case. Some lubricants fit the viscosity and additive parameters for multiple machine types, but some
lubricants will only meet the parameters of one specific machine. We consolidate and optimize lubricants in order to reach extend machinery life and optimize machinery performance. That is the ultimate goal of machinery reliability. ML
Paul Farless is an Associate Technical Consultant for Noria Corporation. His duties include collecting data and
preparing reports for the engineering team. Prior to joining Noria, Paul worked as an automotive maintenance technician for an auto-repair service company. He also served four years in the U.S. Navy as a gunner’s mate third-class petty officer and as a seaman deckhand, where he was responsible for the troubleshooting and maintenance of electromechanical and hydraulic systems. A detail-oriented team player, Paul works well in fast-paced environments and uses his military background to excel and maximize efficiency.

LUBRICANT RECEPTION & STORAGE
Factor: R1P
A few drums of oil were just delivered onsite and are sitting in front of the warehouse area. What now? Just put them inside and mark them as part of the inventory? Is that it?
No.
Checklists For New Lubricant Deliveries:
Factor: R1P — Quality Control Process
Level:
KPIs(K)
Stage:

Lubricant Reception And Storage
About:
Quality Control Process: The quality control process for new lubricants should be formed in collaboration with the lubricant suppliers and should establish a methodology with which lubricant characteristics can be inspected and evaluated.

Learn More: noria.com/ascend/

• Delivery Requisition Check
• Packaging Integrity Check
• Lubricant Quality Check
• Safety and Storage Check
Delivery Requisition Check
Upon delivery, the receiving clerk at the warehousing area should begin by verifying the lubricants being delivered meet the requirements of the original purchase requisition. This includes:
• On Time: Were they delivered in a timely manner, in the right place and in the requested packaging?
• Right Product: Look at the label — are these the products

Once the product delivered is verified to meet what was requested, a check must be made to verify the product integrity. Lubricants are delivered in many different ways, and inspections must be taken after the oil arrives.
Look for signs of:
• Degradation of or any illegibility on labeling (sticker, embossed, stamp, etc.)
• Broken seals on bungs, covers, gaskets, lids, etc.
• Leaks, drips, puddles of oil, grease smudges, etc.
• Corrosion on metal containers or any external body surface damage
• Particulate contaminant build-up in crevices on container design, especially near oil fill and drain points

• Water build-up evidence in pockets or areas near the ground, indicating evidence of outdoor storage
Look for signs of:
• Cuts, indentions or dings from poor handling (possibly due to boxes stacked too high, pressing down on products inside)
(jugs, cans, spray cans)
• Previous oil or grease residue, possibly poor storage conditions (e.g., lubricants packaged in cartons can show signs of leakage on the cardboard)


Look for signs of:
• Suspicious welds indicating repair work
• Pitting
• Deformed containers, such as folds or creases when indentions exist, or previous indentions have been pressed or punched out
Look for signs of:
• Brittle fractures, cracks
• Dried out appearances
• Bends, indentions, folds
• Pitting
• Evaluate longitudinal and hoop stress
• Tank bottom, especially in ground contact areas

• Look at the bung for evidence of a broken seal (since initial fill)
• Any signs of a container having been reused
• Oil level
• Coating and linings

Look for signs of:
• Evidence of being stored on floors
• Tube direction
• Age

Look for signs of:
• Bung open
• Pipe connections open
• Federal guidelines provided
• Quick connects
• Sediment build-up
• Quick connects closed
• Moisture in headspace (condensation)
Look for signs of:
• Does it look oxidized (changes in appearance)
• Oil separation
• Tankers/Bulk

• Corrosion, body damage
• Leaks
• Cracking on plastic
• Bends
• Indentions
• Deterioration
• Check seals
requested? The product name must be verified in its entirety, not just a similar product.
• Blend Date: Were the lubricants blended on a reasonably recent date? The shelf life of a lubricant starts from the date it is first blended.

• Point of Fill: Ask the delivery representative where the lubricant came from and if the point of fill is known. Has there been any intermediate storage locations? What are the conditions of these locations?
• Certificate of Analysis (COA): Is a COA provided? Each lubricant blended at a blend plant should be analyzed to verify the product’s physical, chemical
and performance properties. This will include lubricant analysis testing such as viscosity, oxidation stability, elemental analysis, FTIR and cleanliness.
Bennett Fitch is the Chief Strategy Officer for Noria Corporation. He is a mechanical engineer, holding certifications in Machinery Lubrication Engineer (MLE), MLA Level III, and a MLT Level II through the International Council for Machinery Lubrication. Contact Bennett at bfitch@ noria.com.

Factor: H4M
Factor:
H4M — Lubrication
Program Management
Level: Platform (M)
Stage: Lubricant Handling & Application


About:
Lubrication Program Management: Managing a lubrication program with specifically designed software allows tasks to be efficiently monitored, scheduled and executed.
Learn More:
noria.com/ascend/
I’ve spent the past week helping a client get their lubrication program back on track. It seems that we visited their site a few years ago, but the company (having been bought by another company) changed over in leadership a number of times; a lack of communication while people were rotating out of their positions left the organization in a bit of a pinch.
They did have some things going for them, though: a lubrication room had been built; they had purchased filter carts, sealable and reusable top-up containers; they even color-coded quick connects
— all very nice elements for a lubrication program. The issue was that all this equipment was purchased about five years prior. The lube room had been built, but everything just got tossed onto a shelf or into the room.
I know you’re asking, “what’s wrong with the lubrication stuff being put in the lube room?” Well, nothing at all is wrong with storing lubrication-related items in a lube room, but everything else that they didn’t know where to put ended up going in there as well: ladders, random parts, empty boxes, paint, exploded batteries — you name it. The lube room just became a collection chamber for
random items. Additionally, half of the facility had switched to a national lube supplier since being bought, and the other half was lagging by two years in making the switch.
I’m not one to concern myself with the “where” when it comes to companies sourcing their lubricants, but this specific facility brought issues onto themselves. Pails of both oil and grease that were seven or more years old were sitting in the back of this nice lube room; some of these lubricants had been ordered by accident, some due to miscommunication and others because the person tasked with placing the order


didn’t understand what they were ordering to begin with.
It gets worse. The client had invested quite a bit in very nice hardware and tools: moisture testing kits, acid number test kits, viscometers and even a patch test kit. None of these items were anywhere to be found. Storerooms had changed locations over the years, along with inventory management software and the CMMS. So even though the company had invested in all this stuff, it was either tossed at some point or just vanished into thin air.
Now, I understand that when it comes to parts, electronics and tools, things are typically tracked rather well (for the most part), but people tend to treat lubricationrelated items as disposable. This is a big mistake. Our lubricants are assets, just like our equipment and tools, and we should treat them as such. This means that by implementing proper inventory control, we never have to ask “what’s in the box.”
Inventory management should be approached in a lean manufacturing type of mind frame. We want to minimize loss and maximize effort. This lets you take control of your inventory, control costs and avoid unnecessary downtime. Just as with the manufacturing process, there are key components that we have to start taking seriously:

When we are in the store picking up milk or items that expire, we typically grab the item that will last the longest or has the most prolonged time before it expires. We don’t really have this luxury in our facilities. We already own the stuff on our shelves, so it is up to us to ensure that we are using the oldest items first so that we don’t end up with old (and possibly bad) lubricants in our equipment.
I often go into facilities and ask them where their lubricants are stored. Then I get a tour of the facility, my guide pointing to random places: lean-tos with drums in them, shipping containers with random stuff piled in, a battalion of mechanics’ carts or pallets just sitting outside in a yard somewhere. With everything spread around like this, it is next to impossible to know what you have on hand at any given point.
Why do we insist on keeping lubricants that we don’t use? If you change from one supplier to a different one, either use up all the previous supply or just get rid of it. By keeping these no-longerused lubricants on hand, you are facilitating (almost encouraging) cross-contamination. You’re using up precious real estate as well. By having one centralized location through which all lubricants pass, you can more easily keep inventory and know how much lubricant you are actually going through.

If you know that you have 25 gear boxes that take the same ISO 220 lubricant, and they all hold 10 gallons of oil, it is pretty easy to go through 250 gallons if you are doing annual oil changes; but how often do you
change the oil on absolutely every gear box? Do you need to have 250 gallons of this lubricant on hand all the time? Talk to your supplier/ distributor about how often you do these oil changes and compare that with how often you receive lubricant shipments. You may only need to keep 5-55 gallons on hand to meet typical use. This is your minimum on-hand amount, and this technique can be used for all of your lubricants. Take measure of your bearings: how much grease they get and how often they get regreased; compare this to the way you receive the grease (tubes, kegs, drums, etc.), and you can get to your minimum on-hand amount.
Knowing how to properly apply and handle lubricants is a skilled task. Just as you wouldn’t send the average operator into the machine shop and
expect them to be able to create parts on a CNC machine, you shouldn’t expect random people in your facility to just know how to properly use and apply lubricants. Have your lubrication tasks performed by those who have the skill and knowledge to do it right. This ensures that the job is getting done by professionals, and we don’t have to ask questions like, “why do we keep running out of our electric motor grease — we only grease our motors twice a year, and they don’t take that much?” (SPOILER ALERT: the untrained folks that you are allowing to apply lubricants are likely putting whatever is handy into whatever is squeaking.)
Many people look at 5S/6S as some superfluous thing that just takes time to set up and has no intrinsic value. These people are wrong. Everything about 5S/6S directly applies to lean practices and simplifies inventory management
for those controlling stock and those who use the items. A well-stocked luberoom benefits from having everything stored in a manner that allows anyone who walks in to recognize what is kept where, what items are missing, what stock is low and even the condition of our equipment (be it grease guns, single point lubricators or top-up containers). ML
Jeremie Edwards is an Associate Technical Consultant at Noria Corporation. He is one of an elite few certified by the International Council for Machinery Lubrication (ICML) as a Machinery Lubrication Engineer (MLE) and did so in order to become the best advisor for clients when it comes to their continuing education needs. Before joining Noria, Jeremie served six years in the U.S. Army as a parachute rigger and was deployed in Afghanistan, Uzbekistan, Turkey and Germany. Contact Jeremie at jedwards@noria.com


Factor: C3M — Contamination
Control Objectives
Level: Management and Training(M)
Stage: Contamination Control & Lubricant
Reconditioning
About: Implementing contamination control objectives and goals increases machine reliability. Highly critical machines should have stringent objectives.
Learn More: noria.com/ascend/

Factor: C3M
Maintenance is the single most controllable expense in a facility. These words have been quoted time and time again, vis-à-vis controlling equipment failures. Few areas of focus are more impactful on managing expenses than contamination control. However, in the quest for the cleanest achievable oil, some questions typically form: How much filtration is too much filtration?
Is there such a thing as oil that is too clean? While the questions are simple and straightforward, the answers are anything but, and include a variety of variables that many don’t account for when starting a fluid cleanliness program.
Among the first variables that I address when helping a customer develop a contamination control program is the type of fluid in question. Most industrial facilities will employ a range of lubricants for different machine types and environments. Determining where the focus should be for filtration

begins with determining which fluids actually require filtration. That’s right — not all lubricants may need to be filtered prior to use.
Let’s start with looking at equipment where the results of contamination are low or where it may not be economically feasible to filter the lubricant. Typically, the first machines in this category tend to be total-
loss systems or those completely exposed to the environment. Total-loss equipment (where the lubricant is applied and then drains, evaporates or is otherwise consumed) may not require filtration, provided the applied lubricant doesn’t impact the delivery mechanism. For instance, if we are using a spray or drip system, the lubricant needs to be free of solids that would clog the nozzles or piping but not necessarily much cleaner than that. In systems that operate while freely exposed to the environment


(such as open gearing and drive chains), the ambient contaminants will stick to the oil-wetted surfaces, rendering any prior filtration activities useless. In these cases, most will find that filtration is too costly for any benefit that is obtained.
The equipment at the opposite end of this spectrum operates at high speeds and loads and has tight dynamic tolerances. Typically, hydraulics will require the cleanest oil of any system in our facilities, followed closely by turbine systems and bearing lubricants. While other equipment benefits from cleaner oil, the primary focus on cleanliness should be here. Gearboxes, engines and compressors can have slightly higher contaminated fluid and still function well. Once we start focusing on the machine type, we are forced to dive into the lubricant type.
For the sake of this discussion, we will focus solely on oils, as greases are not commonly filtered, and there are more factors to be concerned with in their formulation. Lubricating oils that are used in heavily loaded systems, such as gears, are increasingly likely to be formulated with any number of solid additives.
Defoamants can be affected by very stringent filtration conditions. While the additives’ physical size makes a difference in this process, the issue comes when the concentration of these additives is too high, typically after someone adds a retrofit kit to try and remedy a high foam condition. Once the concentration is too high, the additives are not able to exist in the semidissolved state that allows them to slip through the pores of most filters. Once these additives are removed, the oil is more prone to foaming tendency and stability.
Another common additive type found
in highly loaded systems is solid extreme pressure or anti-scuff additives. These come in many forms with different chemical and atomic structures but are not dissolved; rather, they are suspended in the oil. Tight filtration removes these additives, and the machine suffers more catastrophic wear in high-contact zones — especially those with sliding motion. Additionally, each additive type will have a common size that must be considered when selecting a filter to use. For instance, if we are using a gear oil with a Molybdenum Disulfide additive at a size of ten microns, we would try to avoid filtering down to that level (and lower) to preserve the additive.
Other fluids may not have a solid additive in them but may instead have many dissolved additives: these too can be filtered out, but the process is different than the physical trapping previously mentioned. Many additives function based on polarity (the natural attraction to other polar items) inside the fluid. Some of these additives are very common, such as anti-wear, corrosion inhibitors and dispersants. If a filter media is selected that is an adsorbent type, it attracts these additives due to the polarity, and they are removed from the fluid. Naturally, if these additives are already clinging to a particle or contaminant in the bulk of the oil, and the particle gets trapped
in the filter, the additive level also drops.
While the filter media makes a difference, there are a couple things to look at to determine if it will strip additives. For systems seeking low ISO codes, such as an ISO 16/14/12 or lower, the need to employ a fine filter, such as a three-micron beta 200, becomes more apparent. For higher particle counts, the filter can be larger or the capture efficiency lower. While some additives like the solids mentioned above might be screened out due to size exclusion, others are prone to different mechanisms leading to their removal from the fluid.
Active filter media, such as clay, diatomaceous earth, Fuller’s earth and the like, are very polar. While these may work fine in such applications as Electrohydraulic Control (EHC) systems using Phosphate Esters, we would not want to employ them for work in systems containing high amounts of polar additives, such as gears, compressors or engine oils. These filters have an enormous surface area, and the additives are preferentially sticking to them rather than the machine parts (which can lead to a huge drop in additive levels and performance).
Other filter media types, such as cellulose,

are less prone to stripping additives, but the filtration system can impact this as well. Using full-flow and bypass filtration might not affect additive levels much, but if we employ settling tanks, the story is different. In settling tanks, the additives may fall out of the dissolved state due to a lack of movement or by sticking to other particles that are settling out as well. While settling tanks are a less common mechanism for cleaning oil for industrial equipment, it is common to find the settling out of additives in lubricant storage tanks or even in drums that have been sitting static for an extended time.
A drop in additive levels is normal, and once they drop by approximately twenty-

five percent of their original values, we start to wonder if they are still valid or not. The oil analysis reports are simply stating the number of the concentrations of the signatures found in the oil, not really telling us if they are still active. In order to know for sure, we would have to do some performance testing of the oil to determine if the chemical and physical properties have changed to an unsafe level. It is typically only economically feasible to do this when a large volume of oil is at risk.
Filtration is a great place to start any proactive maintenance program, and by taking sound choices to selection and understanding the risks of over filtration, you can ensure that you are getting the most benefit from your efforts without damaging the oil. ML

Wes Cash is the Vice President of Services for Noria Corporation. He serves as a senior technical consultant for Lubrication Program Development projects and as a senior instructor for Noria's Oil Analysis I and Machinery Lubrication I and II training courses. He holds a Machinery Lubrication Engineer (MLE) Machine Lubrication Technician (MLT) Level II certification and a Machine Lubricant Analyst (MLA) Level III certification through the International Council for Machinery Lubrication (ICML). Contact Wes at wcash@noria.com.
Factor: A4P
Factor:
A4P — Sampling Tools & Methods
Level: Platform (P)
Stage:
Sampling Tools & Methods
About:
Accurate sampling is critical when developing a lubrication analysis program. Inaccurate samples can lead to incorrect decisions regarding machine performance.

Learn More: noria.com/ascend/
What are Microbes?
Also called microorganisms, microbes are microscopic living organisms that can be beneficial or detrimental to human health. Microbes can be grouped into five major categories: viruses, bacteria, archaea, fungi and protists. As humans, we currently have millions of microbes throughout our body,
and current estimates suggest there could be up to 1 billion different species of microbes on earth.

If you have ever taken a level one training with Noria (MLT I or MLA I), you will have heard us compare industrial machinery to the human body: “Take care of your machinery as if you were taking care of your body.”
After COVID-19, we are all well aware of what a virus looks like, how it is potentially transmitted and how harmful it can be to certain people. We can relate that to how detrimental microbial contamination can be in an industrial oil.
When we start feeling sick, we need to perform some basic
diagnostics before we can start healing; a similar approach should be taken with lubrication. What are the symptoms, what is the root cause of the symptoms and how do we fix it? Here are some of the symptoms of microbial contamination:
You should be aware of certain characteristics that may produce a high probability of microbial growth: high
to think of a microbe as a vampire: it needs a stale, moist, dark environment to live in and sucks the blood (oil) from our machines. Unfortunately, however, garlic and a crucifix won’t do much good against microbes; you’re going to need to utilize biocide additives to neutralize the growth of bacteria and eliminate it.
Once eliminated, the oil needs to be dried out as much as possible. To clarify, when I say “dried out,” I mean removing as much water as possible. If drying isn’t possible, then we have to take drastic measures and drain the contaminated oil out of the reservoir. Once drained, a thorough flush of that reservoir with a compatible low viscosity oil that has a biocide additive must be performed.

water levels, stagnant areas, low flow and dark areas. Now, while these symptoms and characteristics may provide a warning, they aren’t necessarily the end all be all; most of the diagnosis of microbial contamination is found through laboratory analysis.
Generally, microbial contamination will produce acid. This happens because the microbe wants to grow and reproduce, and for any living organism to grow and reproduce, it must eat and build energy. What is in an oil that acts as an energy source or food for the microbe? Carbon atoms from the hydrocarbon molecules. Once these structures are broken down and have open bonds, they are more likely to attract oxygen, which produces oxidation, a byproduct of which is acid formation.
I keep referring to the level one training that we provide; in that training, you will hear about keeping oil “clean, cool and dry” no less than a hundred times (with “clean” and “dry’ being the two most important factors as far as microbial contamination is concerned).

As previously stated, microbes need a dark and dank area to thrive. To remember how a microorganism works, it helps me
We need to proactively ensure that we are aggressively preventing water ingression. This can be done by utilizing the right breather or, in some cases, dry instrument air. Make sure that all of the seals and ports are water and air-tight. Install quick connects for draining, filling, topping off and filtering to help prevent contaminant ingression. Use the correct filters with precisely calculated beta ratios and efficiency. Set target cleanliness and dryness goals for your critical machinery (remember, microbe growth can potentially occur at water levels > 500ppm). Lastly, and most importantly, perform frequent oil sampling, inspections and condition monitoring. This will ensure that if microbial growth starts to happen, you can catch it before it is too late. Hopefully, this helps you approach microbial contamination in a calculated manner and helps your machines run better and longer. ML
Paul Farless is an industrial service technician for Noria Corporation. He holds a Machine Lubricant Analyst Level II certification through the International Council for Machinery Lubrication . His duties include collecting data and preparing reports for the engineering team. A detail-oriented team player, Paul works well in fast-paced environments and uses his military background to excel and maximize efficiency. Contact Paul at pfarless@ noria.com.
Factor: E5K
about this ASCEND
More
Factor:
E5K — Energy Conservation, Health & Environmental KPIs

Level: Platform (K)
Stage: Energy Conservation, Health & Environment

About:
A measure of the number of machines that have engineered regrease volume calculations —
Simply put, this is a measure of how often lubricants are being changed in machines. This can be tracked by averaging the number of days between oil changes for all equipment. Changing lubricants more frequently will create a higher volume of total lubricants disposed of at the year’s end. There are a few ways to lengthen oil change intervals, such as using synthetic lubricants or switching to condition-based oil changes. Synthetic lubricants are built to withstand higher temperatures and other extreme conditions — they are generally able to last longer than most mineral oils. Condition-based oil changes use technologies such as oil analysis to identify when an oil needs to be changed instead of using time-based intervals.
Learn More: noria.com/ascend/
How does your plant
Are you tracking the right metrics to see how environmentally friendly your program is doing? Try implementing these KPIs and remember to be consistent and trend the data.
If you are putting in 1000 gallons of lubricant into your machines in a year and only disposing of 750 gallons, there is a potential concern for where the missing 250 gallons will end up. Are your lubricants leaking into the process and ending up in the finished product? Are the leaking lubricants ending up on the floor or in your wastewater? Another potential reason these numbers could be off is that the technician dumping lubricants into the used oil bin is failing to document it.
Leaking lubricants pose a real threat to the environment by working their way into the process or the waste system. In addition to this, if you are continually adding lubricants to a system, you are adding to the total amount of lubricants that need to be disposed of. By addressing leaks found on-site, you are adding to the lubricant residence time. A KPI that could be coupled with this one is how many days, on average, it takes to repair leaks.
Travis Richardson is a technical consultant for Noria Corporation. He holds a Level II Machine Lubrication Technician (MLT) certification and a Level III Machine Lubricant Analyst (MLA) certification through the International Council for Machinery Lubrication (ICML). Contact Travis at trichardson@noria. com.

Optimal lubrication is a critical consideration in any production process. In food and beverage production specifically, a balance must be struck; machinery lubrication and food safety are both important. While machines need to be lubricated for smooth operations, care must be taken to avoid chemical contamination. Using food-grade lubricants — and using them in a correct manner — is one way to mitigate food contamination resulting from chemical contact. Food-grade lubricants are made with base stocks and additives that are safe for use around food processing areas. The National Sanitation Foundation (NSF) International registers a wide range of chemical compounds used in products, including lubricants, that comply with

“In food and beverage production, machinery lubrication and food safety are both important.”Erica McDonald | Sr. Product Specialist | CITGO
key regional and global food safety guidelines as well as industry regulations.

NSF’s registration marks are often one of the few that are accepted by food and beverage companies globally. NSF registration demonstrates that a lubricant is aligned with food safety practices adopted by global regulatory agencies.








for allowable substances used in the formulation of food-grade lubricants are contained in the Code of Federal Regulations (CFR) Title 21. Food-grade lubricants must be formulated to meet U.S. FDA 21 CFR 178.3570.
Using a food-grade lubricant can also be a proactive part of a plant’s Hazard Analysis Critical Control Point (HACCP) system. HACCP is a science-based system aimed at controlling food safety hazards within the plant as a way of mitigating the risk of food contamination. An HACCP certification comes highly recommended as it demonstrates a commitment to food safety from harvest to consumption. Prerequisite programs, such as Current Good Manufacturing Practices (cGMP), are required for an HACCP certification. Prerequisite programs are geared towards ensuring necessary environmental and operating conditions are adhered to in a food production setting.






HACCP is built upon seven basic principles:
• Hazard analysis
• Critical Control Points (CCPs) identification
• Establishing critical limits
• Monitoring procedures
• Corrective actions
• Verification procedures
• Record-keeping and documentation procedures
So, what are NSF’s compliance programs for food-grade lubricants and why are they important?
Quality and purity are of utmost importance in a food and beverage production line, and the NSF has various registrations which are based on the USDA White Book. These registrations address the level of contact a lubricant can have with food and the level of risk associated with each. They include 3H, H1, H2 and H3 lubricants.









NSF also certifies (and lists online) products that meet ISO 21469 standards for food-grade lubricants. ISO 21469 is a step-up from H1 registrations as it goes beyond formulations and ingredients and includes quality control and risk assessments. Guidelines

Best-practice facilities create and maintain a comprehensive HACCP plan. Some food processing facilities have also implemented color-coding as a part of their HACCP plan. A color coding system also helps to reduce product mix-ups in a diverse and multi-lingual setting.

Direct contact, 3H lubricants are used as release agents on baking pans, dough dividers, cutters, knives, trays, grills, pans, hooks and other food processing equipment. The lubricants can also be used as a coating on eggs, fruits and vegetables and as a defoaming agent. 3H lubricants are also used as floats to protect the surface of wine and vinegar from air exposure and as a grain dust control agent.
H1 lubricants perform the same basic functions as conventional lubricants while maintaining compliance with food safety regulations. Depending on the application of use, H1 food-grade lubricants are formulated to provide protection against rust, wear and corrosion. Extreme pressure properties and oxidation stability are examples of features that may be found in H1 food-grade lubricants. These lubricants must also maintain compatibility with commonly used elastomers often used in seals. H1 lubricants can be used as antirust agents or release agents on gaskets and seals. Food-grade hydraulic fluids, greases and gear lubricants are common H1 lubricants used in food processing facilities.
Adopting proper storage and handling of food-grade lubricants is another method to help prevent cross-contamination. Food-grade lubricants should be properly identified. It is a best practice to keep foodgrade lubricants in separate storage, away from non-food-grade lubricants. Separating food-grade lubricants from conventional non-food-grade lubricants reduces potential lubricant contamination as well. Shelf life
and storage guidelines can be obtained from your lubricant manufacturer. Generally, food-grade lubricants should always be stored in a cool, dry environment. The additives and ingredients used to formulate the product will determine the shelf life of the lubricant.
Lubricant facilities must ensure that lubricants are properly labeled. Proper labeling and easily-accessible safety data sheets support correct product handling and usage. As an added safety measure,
facilities could set apart designated containers, dispensers, and applicators for food-grade lubricants as well.
It is important to know how to identify food-grade lubricants, their different uses in food processing areas, storage and handling procedures and where they fit in a plant’s HACCP plan. Food grade lubricants are specifically formulated to ensure optimal lubrication for machinery while minimizing the risk of lubricant cross-contamination. ML
The 13th edition of the (ISFL)-2023, the flagship symposium of the O&G sector focusing on global R&D developments, was held during 17 – 19 March 2023 in Delhi NCR. It was inaugurated by Chief Guest, Mr Pankaj Jain, Secretary, Ministry of Petroleum & Natural Gas (MoP &NG). He said that India is already on an inclusive, ambitious and action-oriented path to attain Net-Zero by 2070. Dr SSV Ramakumar, Director (R&D), Indian Oil


and Chairman NSC, ISFL 2023 said at the valedictory session of the conference, “With a strength of nearly 500 delegates from
13 nationalities drawn from about 100 organizations, ISFL-2023 was technically intense, a grand success and rewarding.”
13th International Symposium on Fuels and Lubricants (ISFL 2023) organized by Indian Oil R&D under the aegis of ISFL Society
The “Lube-Tips” section of Machinery Lubrication magazine features innovative ideas submitted by our readers.

When viewing sight glasses, always wipe the glass off with a white grease rag and then turn the rag over and hold the clean side opposite the side you are viewing. The white background lets you see the oil more clearly.

Color code your grease fittings with plastic caps. At my facility, we have white for high speed (heavy)grease, red for regular (slow speed) grease and blue for electrical. Plastic caps are relatively cheap and easy to identify.
Additional tips can be found in our Lube-Tips email newsletter. To receive the Lube-Tips newsletter, subscribe now at MachineryLubrication.com.
If you have a tip to share, email it to editor@noria.com.
Put the date that a consumable item (spin-on filter, automatic lubricator, etc.) should be changed instead of the date of installation. For replacement purposes, it is easier to recognize a date coming up than to add time to a past date. ML

This month, Machinery Lubrication continues its “Test Your Knowledge” section, in which we focus on a group of questions from Noria’s Practice Exam for Level I Machine Lubrication Technician and Machine Lubricant Analyst. The answers are located at the bottom of this page. Practice Questions supplied by Noria Academy. Visit Noria.com/Academy to learn more.

1. The total amount of oil purchased in a year divided by the total amount of oil held by a group of machines is known as?
A. Oil consumption percentage
B. Oil conversion rate
C. Oil consumption ratio
D. Oil purchasing ratio
2. If an SAE 20 oil is blended in equal parts with an SAE 40 oil, what will the resulting SAE grade be?
A. SAE 20
B. SAE 30
C. SAE 60
D. SAE 10W-30
3. How many of the API base stock groups include mineral oils?
A. One
B. Two
C. Three
D. Four
4. What is VHVI an abbreviation for?
A. Valuable high viscosity item
B. Very high vacuum index
C. Very high viscosity index
D. Variable heat viscosity interval
5. Which type of lubrication system uses reclassifiers?
A. Wick feed
B. Oil mist
C. Single-line progressive
D. Duel-line parallel

Bharat Petroleum Corporation Limited (BPCL) has appointed G. Krishnakumar as the Chairman and Managing Director of the company. Krishnakumar has been associated with BPCL for 36-years, leading the organisation’s customer-centric ventures into convenience retailing, premium fuels and new tech and digital initiatives in the company. "Krishnakumar has developed and nurtured winning brands like Petro Card, SmartFleet, Speed, In & Out, which have been significant contributors
to BPCL’s differentiated customer value proposition in the marketplace, reinforcing the Pure for Sure customer promise," said BPCL in a press statement. "He also championed the expansion of the service dimension of the MAK brand - MAK Quik, for quick oil change for 2- wheelers which has since been adopted by millions of customers," BPCL said adding that during his stint as head of learning and development and subsequently as Executive Director (HRD), Krishnakumar led the conceptualisation and implementation
of several path breaking initiatives to bring about a transformation in skilling and leadership development in the organisation, future proofing BPCL in the face of the emerging challenges and the paradigm shifts in the business landscape. Krishnakumar is an electrical engineer from NIT (erstwhile Regional Engineering College), Tiruchirapalli and has done his Masters in Financial Management from Jamnalal Bajaj Institute of Management Studies, Mumbai.
Hindustan Petroleum Corporation Ltd (HPCL) has entered into an agreement with Chevron - to manufacture, distribute, and market lubricants in India. The agreement provides for Caltex-branded lubricants to be manufactured, distributed, and marketed in India by HPCL. Chevron is a subsidiary of Chevron Corporation, and this collaboration encompasses the licensing, production, distribution, and marketing of Chevron's lubricant products under Caltex.

The agreement provides for "Caltexbranded lubricants to be manufactured, distributed, and marketed in India by HPCL".HPCL already has its own brand of lubricants and this would be in addition to the existing ones.
Brant Fish, President of Chevron International Products, stated, "We are extremely pleased to partner with HPCL to bring quality Caltex lubricants technology and performance to India. HPCL is a market leader in India, and together we plan to build on the strength of the Caltex
brand and our premium product portfolio."
Amit Garg, Director of Marketing of HPCL, said, "This exciting partnership paves the way to leverage HPCL's market leadership to add value via a broader, premium product offering to Indian consumers through synergies between HPCL and Chevron.The long-term comprehensive cooperation we have with Chevron is built on HPCL's success in the field of lubricants production, distribution, and marketing. We look forward to a fruitful and long-lasting journey with the Caltex brand in the Indian market."

